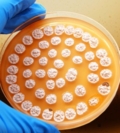

№ 1 Сабақтың тақырыбы:
“ Ветеринарлық микробиология түсінігі”
Сабақ мақсаттары:
-
Білімділік: Оқушыларды ветеринарлық микробиология негіздері мен таныстыру
-
Дамытушылық: ветеринарлық микробиология негіздері бойынша теориялық білімін бекіту.
-
Тәрбиелік: Еңбектенуге, жеке тұлға ретінде қалыптасу мен кәсіби білімдерін іске асыра білуге тәрбиелеу.
Пайдаланған көрнекіліктер: Малдың нақпішіндері, видеопроектор, слайдтар, дидактикалық материал, оқулық Өтенов Ә.М. «Ветеринария негіздері».
Пән аралық байланыс: химия, мал ауру негіздері, мал шаруашылық негіздері, еңбек қауіпсіздігі.
Сабақтың әдісі: машық
Сабақтың өтетін жері: ветеринария кабинеті
Сабақтың барысы:
-
Ұйымдастыру кезеңі: оқушылардың қатысуын, дайындығын тексеру.
-
Кіріспе нұсқау:
Мал мен жұмыс істегендегі еңбек қауіпсіздігін қайталау.
Микробиология – жай көзге көрінбейтін ұсақ тірі организмдерді олардың құрылысымен биологиялық қасиеттерін табиғатта жүріп жатқан процестердегі әрекетін адам тұрмысындағы пайдасы мен зияны жануарлармен адамдарды кездесетін толып жатқан ауруларды қоздыратын жан-жақты зерттейтін ғылым. Ол негізінен үш грек сөзінен тұрады (микрос – кішкене, майда, биос – тіршілік, логос – ғылым). Жалпы микробиология – микроорганизмдердің өзгергіштігі мен тұқым қуалаушылығына, дамуы мен тіршілік етуінің негізгі заңдылықтарына жалпы сипаттама береді, олардың табиғатта заттар алмасу процесіндегі ролін және оны адам баласының пайдасына қолданудың мүмкіндіктерін зерттейді.
Микроорганизмдерге бактериялар микроскоптық саңырауқұлақтар, вирустар және басқа да организмдер жатады. Микроорганизм ішінде тұрмыста көп көмегін тигізіп пайда келтіретін және адам жануарлармен өсімдіктерге көп зиян келтіріп, жойқын әсер ететін топтары да бар. Микробтар жер бетінің барлық түкпірінде таралған. Олар адам баласының өмірлік серігі. Кейде оның жан қияр досы болып көрінсе, кейде қас жауы болып шығады. Көп мөлшерде қолданылатын тағамды, суда, дем алатын ауада кездеседі.
Микробиология ботаника мен зоология ғылымын қарапайым организмдерді зерттейтін салаларымен тығыз байланысты. Ферменттер мен витаминдер зерттеуде микробиология биохимия мен байланысты болып табылады. Микробиология ғылымның қазіргі кезде халық шаруашылық барлық дерлік саласында қолданылады.
Тіршілік тірегі жер ана топырақта жүріп жатқан негізгі биологиялық процестері топырақ құнарлығын құралау барлығы да микроорганизмдер қатысуынсыз мүмкін емес.
Микроорганизмдер малды ас қорыту процесіне
қатысады. Микроорганизмдердің биохимиялық ферментативтік
әрекеттерінің маңызы бір
төбе,
халық
шаруашылығында қажетті заттар спирт, сірке, май қышқылдары, ацетон,
түрлі антибиотиктер,
мал өнімділігін
дәмдеуіш заттары осы микроорганизмдерден алынады. Күнделікті
қолданылатын сыра түрлі шараптар тағамдардың шіруі, бүлінуі,
көгеруі, осы микроорганизмдерден әсер
келеді.
Жалпы
микробиология
Микробиология – микроорганизмдердің
биохимиялық әрекеттерін, қоректік заттарды өзгертудегі олардың
негізгі ролін қарастырады. Бұл процестердің ішінде кейбір
микроорганизмдер әрекеттерінің, мәселен
қанттың спиртке дейін
ашуының, антибиотиктер мен витаминдер түзілуінің халық
шаруашылығында зор маңызы бар. Микроорганизмдер тіршілігінің ең бір
айқын байқалатын жері – ашу
процесі.
Күнделікті көріп жүрген сыра мен түрлі шараптар, тағамдардың шіріп, бүлінуі және көгеруі бәрі де осы микроорганизмдер әсерінен болады. Осы жағдайды еске ала отырып, біз микроорганизмдердің биохимиялық әрекеттеріне ерекше көңіл бөлдік, көптеген биологиялық процестердің негізін толығырақ баяндауға тырыстық.
С онымен қатар микробиологияның отан қорғау жөнінде де алатын орны
ерекше. Дүние жүзілік үстемдікке құмар империалистер көздеген мақсаттарына жетуге барлық
айла-амалдарын қолданудан бас тартпайды. Мұны тарих көрсетіп отыр.
Қазір кейбір капиталистік мемлекеттер микроорганизмдердің адам мен
жануарлардың өміріне қауіпті аурулардың тууына себепші болатын
әрекеттерін соғыс мақсатына пайдалануды көздеп отыр. Олар
антибиотиктердің өзі қарсы тұра алмайтын микроорганизмдердің
қасиеттерін күшейтіп, оны әр түрлі жәндіктерге (маса, сона, шіркей,
шыбын, бүрге т.т) жұқтырып қолданбақ. Өйткені мұндай жәндіктер
жұқпалы ауруды ауылдар мен қалаларға тез таратып, жаппай қырғынға
ұшырау қаупін тудырады. Ол үшін микроорганизмдерді жан-жақты
зерттеп, жете талдау керек. Сонда ғана олардың қауіпті әрекеттерін
біліп қана қоймай, нақты күрес шараларын белгілеп, келтіретін
пайдасын да білуімізге болады
онымен қатар микробиологияның отан қорғау жөнінде де алатын орны
ерекше. Дүние жүзілік үстемдікке құмар империалистер көздеген мақсаттарына жетуге барлық
айла-амалдарын қолданудан бас тартпайды. Мұны тарих көрсетіп отыр.
Қазір кейбір капиталистік мемлекеттер микроорганизмдердің адам мен
жануарлардың өміріне қауіпті аурулардың тууына себепші болатын
әрекеттерін соғыс мақсатына пайдалануды көздеп отыр. Олар
антибиотиктердің өзі қарсы тұра алмайтын микроорганизмдердің
қасиеттерін күшейтіп, оны әр түрлі жәндіктерге (маса, сона, шіркей,
шыбын, бүрге т.т) жұқтырып қолданбақ. Өйткені мұндай жәндіктер
жұқпалы ауруды ауылдар мен қалаларға тез таратып, жаппай қырғынға
ұшырау қаупін тудырады. Ол үшін микроорганизмдерді жан-жақты
зерттеп, жете талдау керек. Сонда ғана олардың қауіпті әрекеттерін
біліп қана қоймай, нақты күрес шараларын белгілеп, келтіретін
пайдасын да білуімізге болады





Ағымды нұсқау:
-
Өзіндік жұмыс тапсырмасы
Жұмыс дәптеріне зерттеу нәтижелерін толтыру:
-
Жұмыртқа микрофлорасы.
-
Тері өнімдерінің микрофлорасы.
-
Бағалы тері заттарының микрофлорасы.
-
Ішек микрофлорасы.
Пысықтау сұрақтары:
-
Микроорганизмдерге физикалық факторлардың әсері
-
Микроорганизмдерге химиялық факхорлардың осері
-
Микроорганизмдерге биологиялық факторлардың әсері
-
Микроорганизмдерді өсіретін қоректік орталар
-
Микроорганизмдердің генетикасы мен селекциясы
-
Микроорганизмдердің өзара және баска тіршілік иелерімен катынасы
-
Қорытынды нұсқау:
Сабақ тиісті қорытындыланып, бағаланды
-
Ұй тапсырмасы:
Өтенов Ә.М. “Ветеринария негіздері”
жүктеу мүмкіндігіне ие боласыз
Бұл материал сайт қолданушысы жариялаған. Материалдың ішінде жазылған барлық ақпаратқа жауапкершілікті жариялаған қолданушы жауап береді. Ұстаз тілегі тек ақпаратты таратуға қолдау көрсетеді. Егер материал сіздің авторлық құқығыңызды бұзған болса немесе басқа да себептермен сайттан өшіру керек деп ойласаңыз осында жазыңыз
“Ветеринарлық микробиология түсінігі”
“Ветеринарлық микробиология түсінігі”
№ 1 Сабақтың тақырыбы:
“ Ветеринарлық микробиология түсінігі”
Сабақ мақсаттары:
-
Білімділік: Оқушыларды ветеринарлық микробиология негіздері мен таныстыру
-
Дамытушылық: ветеринарлық микробиология негіздері бойынша теориялық білімін бекіту.
-
Тәрбиелік: Еңбектенуге, жеке тұлға ретінде қалыптасу мен кәсіби білімдерін іске асыра білуге тәрбиелеу.
Пайдаланған көрнекіліктер: Малдың нақпішіндері, видеопроектор, слайдтар, дидактикалық материал, оқулық Өтенов Ә.М. «Ветеринария негіздері».
Пән аралық байланыс: химия, мал ауру негіздері, мал шаруашылық негіздері, еңбек қауіпсіздігі.
Сабақтың әдісі: машық
Сабақтың өтетін жері: ветеринария кабинеті
Сабақтың барысы:
-
Ұйымдастыру кезеңі: оқушылардың қатысуын, дайындығын тексеру.
-
Кіріспе нұсқау:
Мал мен жұмыс істегендегі еңбек қауіпсіздігін қайталау.
Микробиология – жай көзге көрінбейтін ұсақ тірі организмдерді олардың құрылысымен биологиялық қасиеттерін табиғатта жүріп жатқан процестердегі әрекетін адам тұрмысындағы пайдасы мен зияны жануарлармен адамдарды кездесетін толып жатқан ауруларды қоздыратын жан-жақты зерттейтін ғылым. Ол негізінен үш грек сөзінен тұрады (микрос – кішкене, майда, биос – тіршілік, логос – ғылым). Жалпы микробиология – микроорганизмдердің өзгергіштігі мен тұқым қуалаушылығына, дамуы мен тіршілік етуінің негізгі заңдылықтарына жалпы сипаттама береді, олардың табиғатта заттар алмасу процесіндегі ролін және оны адам баласының пайдасына қолданудың мүмкіндіктерін зерттейді.
Микроорганизмдерге бактериялар микроскоптық саңырауқұлақтар, вирустар және басқа да организмдер жатады. Микроорганизм ішінде тұрмыста көп көмегін тигізіп пайда келтіретін және адам жануарлармен өсімдіктерге көп зиян келтіріп, жойқын әсер ететін топтары да бар. Микробтар жер бетінің барлық түкпірінде таралған. Олар адам баласының өмірлік серігі. Кейде оның жан қияр досы болып көрінсе, кейде қас жауы болып шығады. Көп мөлшерде қолданылатын тағамды, суда, дем алатын ауада кездеседі.
Микробиология ботаника мен зоология ғылымын қарапайым организмдерді зерттейтін салаларымен тығыз байланысты. Ферменттер мен витаминдер зерттеуде микробиология биохимия мен байланысты болып табылады. Микробиология ғылымның қазіргі кезде халық шаруашылық барлық дерлік саласында қолданылады.
Тіршілік тірегі жер ана топырақта жүріп жатқан негізгі биологиялық процестері топырақ құнарлығын құралау барлығы да микроорганизмдер қатысуынсыз мүмкін емес.
Микроорганизмдер малды ас қорыту процесіне
қатысады. Микроорганизмдердің биохимиялық ферментативтік
әрекеттерінің маңызы бір
төбе,
халық
шаруашылығында қажетті заттар спирт, сірке, май қышқылдары, ацетон,
түрлі антибиотиктер,
мал өнімділігін
дәмдеуіш заттары осы микроорганизмдерден алынады. Күнделікті
қолданылатын сыра түрлі шараптар тағамдардың шіруі, бүлінуі,
көгеруі, осы микроорганизмдерден әсер
келеді.
Жалпы
микробиология
Микробиология – микроорганизмдердің
биохимиялық әрекеттерін, қоректік заттарды өзгертудегі олардың
негізгі ролін қарастырады. Бұл процестердің ішінде кейбір
микроорганизмдер әрекеттерінің, мәселен
қанттың спиртке дейін
ашуының, антибиотиктер мен витаминдер түзілуінің халық
шаруашылығында зор маңызы бар. Микроорганизмдер тіршілігінің ең бір
айқын байқалатын жері – ашу
процесі.
Күнделікті көріп жүрген сыра мен түрлі шараптар, тағамдардың шіріп, бүлінуі және көгеруі бәрі де осы микроорганизмдер әсерінен болады. Осы жағдайды еске ала отырып, біз микроорганизмдердің биохимиялық әрекеттеріне ерекше көңіл бөлдік, көптеген биологиялық процестердің негізін толығырақ баяндауға тырыстық.
С онымен қатар микробиологияның отан қорғау жөнінде де алатын орны
ерекше. Дүние жүзілік үстемдікке құмар империалистер көздеген мақсаттарына жетуге барлық
айла-амалдарын қолданудан бас тартпайды. Мұны тарих көрсетіп отыр.
Қазір кейбір капиталистік мемлекеттер микроорганизмдердің адам мен
жануарлардың өміріне қауіпті аурулардың тууына себепші болатын
әрекеттерін соғыс мақсатына пайдалануды көздеп отыр. Олар
антибиотиктердің өзі қарсы тұра алмайтын микроорганизмдердің
қасиеттерін күшейтіп, оны әр түрлі жәндіктерге (маса, сона, шіркей,
шыбын, бүрге т.т) жұқтырып қолданбақ. Өйткені мұндай жәндіктер
жұқпалы ауруды ауылдар мен қалаларға тез таратып, жаппай қырғынға
ұшырау қаупін тудырады. Ол үшін микроорганизмдерді жан-жақты
зерттеп, жете талдау керек. Сонда ғана олардың қауіпті әрекеттерін
біліп қана қоймай, нақты күрес шараларын белгілеп, келтіретін
пайдасын да білуімізге болады
онымен қатар микробиологияның отан қорғау жөнінде де алатын орны
ерекше. Дүние жүзілік үстемдікке құмар империалистер көздеген мақсаттарына жетуге барлық
айла-амалдарын қолданудан бас тартпайды. Мұны тарих көрсетіп отыр.
Қазір кейбір капиталистік мемлекеттер микроорганизмдердің адам мен
жануарлардың өміріне қауіпті аурулардың тууына себепші болатын
әрекеттерін соғыс мақсатына пайдалануды көздеп отыр. Олар
антибиотиктердің өзі қарсы тұра алмайтын микроорганизмдердің
қасиеттерін күшейтіп, оны әр түрлі жәндіктерге (маса, сона, шіркей,
шыбын, бүрге т.т) жұқтырып қолданбақ. Өйткені мұндай жәндіктер
жұқпалы ауруды ауылдар мен қалаларға тез таратып, жаппай қырғынға
ұшырау қаупін тудырады. Ол үшін микроорганизмдерді жан-жақты
зерттеп, жете талдау керек. Сонда ғана олардың қауіпті әрекеттерін
біліп қана қоймай, нақты күрес шараларын белгілеп, келтіретін
пайдасын да білуімізге болады

Ағымды нұсқау:
-
Өзіндік жұмыс тапсырмасы
Жұмыс дәптеріне зерттеу нәтижелерін толтыру:
-
Жұмыртқа микрофлорасы.
-
Тері өнімдерінің микрофлорасы.
-
Бағалы тері заттарының микрофлорасы.
-
Ішек микрофлорасы.
Пысықтау сұрақтары:
-
Микроорганизмдерге физикалық факторлардың әсері
-
Микроорганизмдерге химиялық факхорлардың осері
-
Микроорганизмдерге биологиялық факторлардың әсері
-
Микроорганизмдерді өсіретін қоректік орталар
-
Микроорганизмдердің генетикасы мен селекциясы
-
Микроорганизмдердің өзара және баска тіршілік иелерімен катынасы
-
Қорытынды нұсқау:
Сабақ тиісті қорытындыланып, бағаланды
-
Ұй тапсырмасы:
Өтенов Ә.М. “Ветеринария негіздері”

шағым қалдыра аласыз















